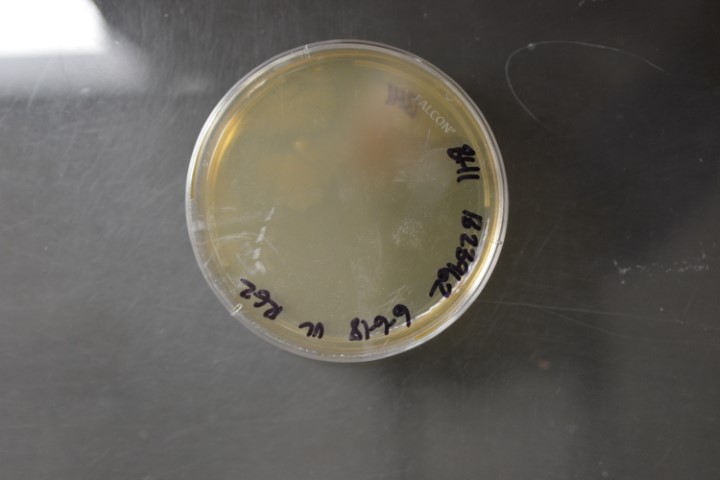

Clostridium perfringens
NRRL B-23962(Type Strain)
Accession numbers in other collections:ATCC 13124=CIP 103409=DSM 756=JCM 1290=KCTC 3269=LMG 11264=NCIB 6125=NCTC 8237
Source:Lee,J.S.(Korean Collection for Type Cultures)
Growth media:Brain Heart Infusion Broth(BHI)(number 34)
Optimum growth temperature:37C
Strain images:
NRRL_B-23962_34.JPG

Comments:type A,alpha-toxigenic,Anaerobic
This strain is a regulated animal pathogen.An APHIS VS 16-3 permit is required for distribution in the United States.For international requests,an importation permit or an official letter from the appropriate government agency declaring that a permit is not required must be provided in advance of shipment.